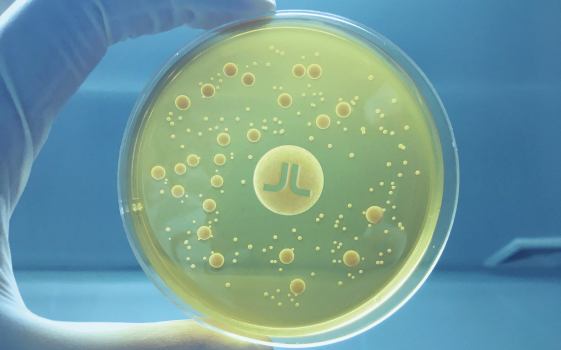

Программы
исследований

Изучение эффективности удобрений в различных почвенно-климатических условиях
Моделирование полевых условий различных климатических зон и типов почв в условиях фитотрона позволяет нашим агрономам с высокой точностью прогнозировать поведение микроорганизмов в составе наших микробиологических удобрений в условиях различных агроклиматических зон. Изучение таких моделей и их сопоставление с физиологией бактерий различных штаммов помогает нашим агрономам уточнять схемы внесения, вписывая обработки в существующие и усовершенствованные технологии производства различных сельскохозяйственных культур.
Изучение влияния биома на плодородие почв и разработка новых продуктов
В основу микробиологических удобрений Азотовит и Фосфатовит легли разработки группы советских ученых, работавших в НПО «Биопрепарат» под Руководством Елизаветы Васильевны Чекасиной. В задачу ученых входила разработка технологии восстановления плодородия почвы после техногенных катастроф. В настоящее время, основываясь на фундаменте многолетнего применения микробиологического NPK-комплекса – Азотовит + Фосфтовит, мы перезапустили масштабную программу исследований влияния микробиома почвы на режим питания растений и состояние агробиоценозов. Активно ведется работа по разработки и тестированию новых микробиологических продуктов и биоминеральных удобрений.

Агрополигоны
В параллели с лабораторной работой, которую мы осуществляем с ведущими научно-исследовательскими институтами, ведется опытная работа на агрополигонах в различных регионах России. На практике в поле наши агрономы отрабатывают научные подходы к совершенствованию системы питания растений. Для наших клиентов организован постоянный доступ на опытные поля, чтобы они могли посмотреть действие удобрений ДельтаБио на различных культурах и получить рекомендации по дальнейшему совершенствованию системы питания растений.